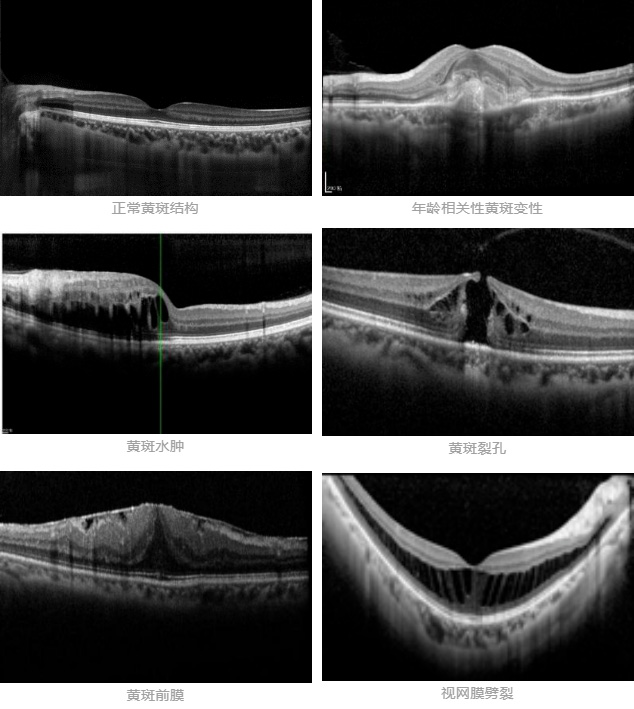
微信截图_20220518085755.jpg 微信截图_20220518085755.jpg

眼科OCT检查是CT吗?
为更好地发挥三甲综合医院社会责任,促进健康科普知识传播,挖掘友谊科普人才,为广大医务人员搭建展示的舞台,北京友谊医院宣传中心、疾病预防控制与感染管理处、工会联合举办北京友谊医院首届“友谊科普有益健康”科普大赛。大赛受到了医院各科室的积极响应,收集到大量优秀的文章、漫画、短视频作品投稿。节选部分科普文章进行展示。
在眼科的OCT检查室里,患者经常会提出这样一些问题:
“医生,这个OCT检查就是眼部CT的一种吧?”
“医生,我是孕妇,我能做OCT吗?”
“医生,我昨天刚做完胸部CT,今天又做眼部的什么CT,这会不会给我的身体带来伤害呀?”
“眼科这个OCT检查是不是得去放射科做呢?”
……
OCT和CT检查之间到底存在着哪些具体的区别呢?今天就让我们一起来讨论,揭秘两者的不同。
01 从名称上来区别
OCT与CT实际上是来源于我们检查方法的英文名称缩写。眼科光学相干断层扫描的英文名字是Optical Coherence Tomography,简称OCT;放射科电子计算机断层扫描的英文名字是Computed Tomography, 简称CT。
02 从设备外观来区别
眼科OCT设备的体积相对较小,患者多采取坐位进行检查;放射科CT设备的体积较大,患者多采取仰卧位检查。

03 从OCT与CT设备的原理上来区别
眼科OCT设备通过光学原理对生物组织成像,是一种高分辨率、非接触性、无创无辐射的检查方法,这项技术使我们能在活体上获得眼前节组织和眼后节组织的断层影像。CT设备是利用X线穿透人体时发生衰减后构成二维投影,传感器接收后经过计算机进行图像重建,获得扫描组织的断层图像。由于CT的本质是X线,所以这项检查需要在特定的检查室操作。
04 两种设备都可用于眼病断层扫描吗?
回答虽然是肯定的,但是两者关注的眼部位置却有所不同。
眼科OCT更多用于眼底黄斑疾病的检查(如年龄相关性黄斑变性、黄斑水肿、黄斑裂孔、黄斑前膜、视网膜劈裂等),设备发出的光线经瞳孔射入后聚焦于黄斑部位,其对于眼底结构的扫描深度仅为2mm,扫描宽度可在3-10mm范围内进行调节。对于超出上述扫描范围的组织结构,OCT设备就会存在一些局限性了。
放射科CT更多用于整个眼球和眼眶及其周围组织的检查。例如眶内肿瘤、眼球后肌肉形态、眼眶外伤和眼眶内异物等。而对于眼底黄斑、视网膜这些细致微小的组织结构,CT扫描尚不能做出很好的识别。
综上所述,眼科OCT检查和放射科的CT检查是完全不同的两种检查技术,医生会根据患者的病情及发病部位来选择最合适的检查方法。现在,您了解了吗?
特别说明:文章中所提到的检查设备参数仅限于北京友谊医院所使用的设备。
- 标签:
上一篇: 你知道吗?眩晕可能要看耳鼻喉科(上)

